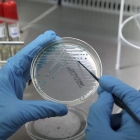

Em seu mais recente relatório anual sobre riscos globais, o Fórum Econômico Mundial (WEF, sigla em inglês) chegou à conclusão que “possivelmente o maior risco….à saúde humana se insere na forma das bactérias resistentes aos antibióticos. Nós vivemos em um mundo onde as bactérias se constituem a maior população do planeta, onde jamais seremos capazes de nos situarmos adiante da curva de mutações das mesmas. Um teste para a nossa resiliência é o quão distante nos permitiremos situar atrás das bactérias nessa curva em que nos colocamos em comparação às mesmas”.
A comunidade se comporta para combater esse alarmante fenômeno da resistência bacteriana; as práticas mais tradicionais, que se caracterizam como os meios atualmente disponíveis para tal são:
- Implementar rigorosamente as práticas reconhecidas de prevenção de infecção hospitalar (lavagem das mãos é exemplo gritante da importância dessas medidas rotineiras);
- Uso correto dos antibióticos atualmente disponíveis, implementando-se cada vez mais o procedimento de escalonamento do antibiótico empregado, levando em consideração os resultados dos exames microbiológicos e a resposta clínica do paciente;
- Desenvolvimento de novos antibióticos.
- Todas essas práticas são essenciais e devem ser mantidas e ressaltadas. No entanto, o relatório do WEF ressalta os fatos de que a resistência aos antibióticos e o colapso na linha de pesquisa e desenvolvimento de novos antimicrobianos persistem crescentes, a despeito dos esforços mantidos em todas essas frentes acima especificadas. Concluem em seu relatório que “caso pretendamos desenvolver medidas que se contraponham a esse panorama de modo duradouro, serão necessárias novas idéias que complementem as abordagens tradicionais”.
Crescimento da resistência antimicrobiana
A ameaça à saúde pública devido ao crescimento da resistência antimicrobiana (RAM) é impulsionada tanto pelo uso adequado como inadequado de medicamentos anti-infecciosos utilizados na saúde humana e animal, bem como na produção de alimentos e, ainda, com medidas inapropriadas para controlar a disseminação de infecções.
Reconhecendo esta crise de saúde pública, vários países, agências internacionais e outras organizações em todo o mundo tomaram medidas para combatê-la através de estratégias aplicadas nos setores relevantes. Várias resoluções da Assembleia Mundial da Saúde têm alertado para ações específicas relacionadas com a RAM. A Organização Mundial da Saúde (OMS) publicou sua estratégia global para conter a RAM em 2001 e, no Dia Mundial da Saúde de 2011, convidou os países a aderirem a um pacote de políticas de seis pontos:
- Compromisso com um plano nacional orçamentário abrangente que seja responsável e envolva a sociedade civil;
- Reforço da vigilância e capacidade laboratorial;
- Garantia de acesso ininterrupto a medicamentos essenciais de qualidade garantida;
- Regulamentação e promoção do uso racional de medicamentos na pecuária e garantia de cuidados adequados ao paciente;
- Aprimoramento da prevenção e do controle de infecções; e
- Promoção de inovação, pesquisa e desenvolvimento de novas ferramentas.
- O livro da OMS A crescente ameaça da resistência antimicrobiana – opções de ação descreve exemplos de políticas e experiências de intervenções relacionadas com a RAM em diferentes partes do mundo. Descreve também alguns dos progressos alcançados desde a publicação da estratégia da OMS de 2001. Chama a atenção para áreas onde não existe o conhecimento e onde são necessárias ações urgentes. O objetivo do livro é sensibilizar sobre a RAM e estimular esforços adicionais para cumprir as recomendações delineadas na estratégia de 2001 e no pacote de políticas do Dia Mundial da Saúde de 2011.
É até difícil imaginar o quão difícil se tornaria nos dias de hoje o manuseio clínico de pacientes submetidos a procedimentos cirúrgicos, transplantes, quimioterapia para câncer, imunossuprimidos pelo HIV ou com doenças graves requerendo cuidados intensivos, caso não fossem disponíveis antimicrobianos eficazes.
As bactérias são campeãs da evolução, sendo que algumas delas se adaptaram de tal forma que passaram a representar gravíssimos desafios clínicos na prática clínica nos dias atuais.
Bactérias gram-positivas
Dentre as bactérias gram-positivas, destacamos os Staphylococcus aureus oxacilina-resistentes (ORSA) e o Enterococcus faecium, que representam enormes desafios terapêuticos nos dias atuais. A evolução dos ORSAs exemplifica a adaptação genética de um microrganismo de forma a se tornar patógeno multirresistente. Após a introdução da penicilina e, posteriormente, das isoxazolilpenicilinas (meticilina e oxacilina), S. aureus rapidamente desenvolveu resistência a esses antibióticos β-lactâmicos; em 2003, mais de 50% dos S. aureus isolados em hospitais americanos eram MRSA.
Nessa época, passou a ser amplamente utilizada a vancomicina para o tratamento dos ORSA quando também se evidenciou o desenvolvimento de resistência aos glicopeptídeos (vancomicina e teicoplanina): de início, essa resistência à vancomicina era de pequena monta, mediada por mutações indefinidas na maioria das vezes. Tais cepas foram denominadas VISA (ou GISA): Staphylococcus aureus intermediariamente resistentes à vancomicina (ou glicopeptídeo).
Subsequentemente, foram relatados isolamentos de cepas de ORSA com elevado grau de resistência à vancomicina (S. aureus vancomicina-resistente ou VRSA). Tal resistência se deve à aquisição do “cluster” de genes vanA, originalmente descritos nos enterococos. Os VRSAs, da mesma forma como verificado com outras cepas de MRSAs que causam infecções em humanos, frequentemente se mostram também resistentes a inúmeras outras drogas, tais como a clindamicina, aminoglicosídeos, sulfametoxazole-trimetoprim, rifampicina e fluoroquinolonas.
Embora sejam menos virulentos quando comparados aos ORSAs, os enterococos desde há muito tempo têm se apresentado como dilemas terapêuticos, inicialmente devido à sua “tolerância” à penicilina e vancomicina (que os inibem, mas não os matam). Esse fenômeno da tolerância já fora descrito no final da década de 1940, quando se relataram casos de falhas no tratamento de endocardites causadas por enterococos (ressaltando-se que os enterococos constituem-se o 3º agente mais comum de endocardites bacterianas), motivo pelo qual passou a ser norma o acréscimo de um aminoglicosídeo à penicilina para o tratamento desses casos. No entanto, é crescente o isolamento de cepas de enterococos com elevado grau de resistência a todos aminoglicosideos, de tal forma que, atualmente, essa combinação sinérgica não é mais útil para o tratamento desses casos de endocardites bacterianas.
Uma série de novos agentes vem sendo utilizada como alternativa à oxacilina e vancomicina, ressaltando-se a linezolida e a daptomicina, já comercialmente disponíveis. A primeira trata-se de antibiótico com atividade bacteriostática, o que limita sua utilidade em casos de infecções que se associam à bacteremia. A segunda tem como principal óbice a seu emprego mais disseminado sua inativação pelo surfactante pulmonar, o que impede sua atividade diante de infecções pulmonares.
Bactérias gram-negativas: ainda mais preocupante
Se a situação é preocupante no que tange às infecções por gram-positivos, é ainda mais alarmante quando nos deparamos com as infecções hospitalares causadas por bactérias gram-negativas.
As infecções causadas por essas bactérias se correlacionam a algumas características particularmente preocupantes. Esses patógenos são altamente eficientes no que concerne à aquisição de material genético que codificam mecanismos associados à resistência bacteriana e, além disso, são também altamente eficientes na otimização da atividade funcional desses genes, em especial quando se deparam com pressão seletiva desencadeada pelo emprego de antibióticos que as inibem de forma inadequada. Além disso, elas têm disponíveis uma ampla gama de mecanismos de resistência, o que faz com que, muitas vezes, empreguem múltiplos mecanismos de resistência contra um determinado antibiótico. Por outro lado, essa riqueza de possibilidades de mecanismos de resistência pode acarretar que um desses mecanismos pode se associar ao desenvolvimento de resistência compartilhado por diferentes antibióticos, mesmo que de famílias diferentes.
Agravante: redução no ritmo de desenvolvimento de novos antibióticos
Complicando ainda mais esse panorama, observa-se expressiva redução no ritmo de desenvolvimento de novos antibióticos por parte da indústria farmacêutica. Estamos, por conseguinte, diante da situação em que ao lado da crescente importância da resistência bacteriana, encontramo-nos carentes do desenvolvimento de novos produtos que contra elas possam apresentar atividade.
Dados recentes do U.S. National Healthcare Safety Network indicam que bactérias gram-negativas são responsáveis por mais de 30% das infecções hospitalares, constituindo-se no agente mais importante nos casos de pneumonias associadas à ventilação mecânica (47%) e também nos casos de infecção do trato urinário (45%).
Nas Unidades de Terapia Intensiva (UTIs) norte-americanas, bactérias gram-negativas são responsáveis por cerca de 70% dos casos dessas infecções, panorama que é também observado em outras regiões do mundo, incluindo o Brasil.
Os dados obtidos através do Sistema NNIS (National Nosocomial Infections Surveillance System) entre 1986 e 2003 puderam determinar a epidemiologia das infecções por bacilos gram-negativos em UTIs no que se refere às principais infecções aí prevalentes: pneumonias, infecções do sítio cirúrgico (ISC), infecções do trato urinário (ITU) e infecções da corrente sanguínea (ICS).
Foram analisadas mais de 410.000 bactérias isoladas de pacientes que adquiriram infecção hospitalar em UTIs no período entre 1986 e 2003. Em 2003, os bacilos gram-negativos foram responsáveis por 23,8% das ICSs, 65,2% dos casos de pneumonia, 33,8% das ISC e por 71,1% dos casos de ITU.
Incrementos significantes nos índices de resistência foram evidenciados de forma uniforme para determinadas combinações patógeno/antimicrobiano. Uma ampla gama de microrganismos gram-negativos é responsável pelas infecções intra-hospitalares, sendo bactérias da família Enterobacteriaceae as mais comumente identificadas.
Desafortunadamente, microrganismos multirresistentes, incluindo-se Pseudomonas aeruginosa, Acinetobacter baumannii e bactérias da família Enterobacteriaceae produtoras de β-lactamases de espectro expandido (ESBL) ou, ainda mais preocupantemente, produtoras de carbapenemase, são cada vez mais comumente relatadas em todo o mundo.
Muito embora as bactérias multirresistentes Pseudomonas aeruginosa, Klebsiella pneumoniae produtoras de carbapenemase e acinetobacter sejam reconhecidas como os mais importantes desafios terapêuticos nos dias atuais, essa multi-resistência se expandiu à maioria das bactérias da família Enterobacteriaceae, de modo que se tornaram também resistentes à maioria dos antimicrobianos, inclusive aqueles mais potentes.
É também preocupante a identificação de que essas bactérias gram-negativas multi-resistentes vêm também sendo isoladas em pacientes previamente saudáveis, fora do ambiente hospitalar. Exemplo dessa situação são os casos de ITUs causadas por E. coli resistentes ao sulfametoxazole-trimetoprim, fluoroquinolonas ou a ambos e que também é produtora de ESBL8.
Até recentemente os antibióticos carbapenêmicos, a exemplo do meropenem e imipenem, sempre apresentavam quase invariavelmente atividade diante dos microrganismos gram-negativos; algumas cepas dessas bactérias desenvolveram maneiras muito eficazes para lidar com os antibióticos dessa classe:
Produção de β-lactamases (denominadas carbapenemases), que acarretam a desintegração da molécula do antibiótico;
Alterações nas porinas presentes na membrana externa das bactérias, que acabam por bloquear a entrada desses antibióticos;
“Bombeamento” ativo da molécula do antibiótico para o exterior da célula bacteriana, utilizando-se das denominadas “bombas de efluxo”.
O quadro fica ainda mais alarmante à medida em que essas barreiras de permeabilidade, assim como as “bombas” de efluxo acabam por atuar também diante de outras classes de antibióticos (por exemplo, quinolonas, aminoglicosídeos e tigeciclina).
Deparando-se com panorama tão nebuloso, os infectologistas e clínicos se voltam muitas vezes para fármacos desenvolvidos há décadas e que, por seus baixos índices atuais de resistência, são resgatados à linha de frente com resultados práticos surpreendentes.
A reciclagem dos antibióticos e a criatividade do médico certamente se constituem em fatores que podem ajudar a nos defrontarmos com panorama tão sombrio.